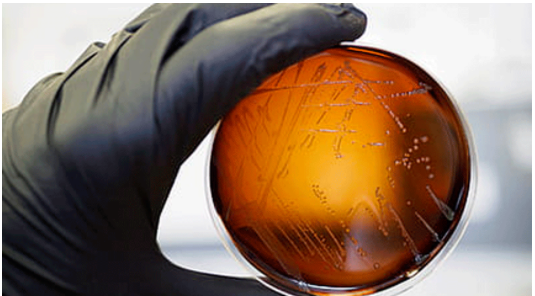

吃早餐的时候,一不小心面包掉到地上,你会立马捡起继续吃,还是选择扔掉?
选择捡起来继续吃的朋友是不是认为——面包掉地上才几秒钟,应该不会沾上什么细菌吧?
如果你真的这样想,那就大错特错了。
食品科学研究的道森教授等研究学者,通过一系列的实验证明:无论食物掉在地上多少秒,地上的细菌都会立即转移到食物里。

细菌
细菌无处不在,它们藏在生活中的物品、食物,乃至我们的手、肠胃等地方。虽然大部分细菌是无害的,但是也有一些细菌爱“搞破坏”。
尤其是在高温季节,更易滋生细菌。及早预防,才能保住健康。
01、藏在蛋里的沙门氏菌
沙门氏菌一般在家禽的肠道里寄存,并且通过血液循环感染全身。家禽肉类、蛋类、乳制品等都可能会被沙门氏菌污染。
其中,我们常吃的鸡蛋、鸭蛋、鹅蛋等蛋类的蛋壳上,会沾有家禽排泄物,这是滋生沙门氏菌的“摇篮”。
一旦吃了受沙门氏菌感染的食物,6~72小时内会出现腹泻、腹痛、头痛、发烧、恶心、呕吐等症状,并持续4~7天。

沙门氏菌
而今年,新闻也曝出多例沙门氏菌感染事件:今年8月,美国48个州有938人感染沙门氏菌,原因与接触家禽有关;
大家一定要到正规的菜市场买菜,避免选购不新鲜、不及格的家禽肉类、蛋类。
预防
① 肉类、某些剩饭剩菜要彻底加热后再吃;
② 避免吃生的食物,如生鸡蛋、生肉;
③ 家用砧板准备2个,分别切生食、熟食。
02、大肠杆菌偏爱
芽苗类蔬菜、不及格餐具
近期,中共大陆杭州一家海底捞火锅,被检测出使用的一批次筷子中的大肠菌群不合格。一时之间,大肠杆菌冲上热搜话题。
大肠杆菌存在我们的肠道里,大多对人体有益处。一项研究表明,大肠杆菌可保护肠道,免受一种名叫“志贺”的致命病菌侵害。

大肠杆菌
不过,当大肠杆菌越来越多或人体免疫力低下时,它就开始“使坏”,致人腹泻、呕吐、胃痉挛等,严重还会导致败血症!
如果我们平时不重视饮食的细节,很容易会招致“坏的大肠杆菌”,如使用不及格的餐具(一次性碗筷)。
此外,由于一些被污染的农田水中含大量大肠杆菌,它们会通过浇灌依附在生长的植被中。
而芽苗类蔬菜(豆芽、豌豆苗等)是最易遭受大肠杆菌污染的菜类。
预防
① 选购新鲜的蔬菜,烹饪前清洗干净;
② 蔬菜要经过高温焯水后再烹饪,煮熟点再吃;
③ 少用不及格的一次性餐具,家中的餐具定时消毒。
03、喂饭方式不对
小孩易感染幽门螺旋杆菌
幽门螺旋杆菌是一种寄生在人体胃部的细菌,它能通过人传人来感染,传播途径有三种:“口口”、“胃口”、“粪口”。
一旦感染这种细菌,会出现上腹部疼痛、口臭、恶心呕吐,不定时出现胃痛、消化不良等不适,令人烦不胜烦。
此外,有研究证实,胃癌患者感染幽门螺旋杆菌的比例高,胃癌的发病率与其有一定的联系。
然而,小孩更易感染幽门螺旋杆菌。

喂饭
有数据显示,中国大陆10岁以下的小孩,受幽门螺旋杆菌感染的几率高达 40%~60%。
预防
① 就餐使用公筷,切忌嚼碎喂孩子吃饭,聚餐时应使用独立的碗筷;
② 注意筷子的清洁、消毒,如果使用木筷子的,建议每隔3个月更换一次;
③ 出门在外,避免吃过多的生冷、辛辣、刺激性食物,否则刺激胃粘膜,降低抵抗力。
04、李斯特菌常年“定居”冰箱里
这种病菌被称为“冷冻杀手”,在2℃~8℃的低温下就能繁殖,它以食物为主要的传染媒介,时刻威胁着人体健康。
不要小看李斯特菌,感染严重者的脑组织会遭受感染,有致命的风险。
而事实上,几个月前也出现了因感染李斯特菌致死的案例:
一款产自韩国的金针菇可能被李斯特菌污染,销往美国后,致30人住院、4人死亡。
李斯特菌
哪些食物可能成为滋养李斯特菌的“摇篮”呢?
瓜果、沙拉、熟食食品(肉类)、软乳酪、肉酱、没有经过高温杀菌的牛奶、没有煮熟的肉类等食物,应尽快吃完。
除了冰箱是李斯特菌的“保险箱”之外,隐秘的砧板、菜刀等餐具上都可能会有它的影子。
预防
① 李斯特菌怕热,食物要经过高温烹饪、彻底加热后再吃;
② 冰箱的生、熟食物要分开,并且定期清理冰箱,避免滋生更多细菌;
③ 生熟食物要用不同的砧板来切,每隔2周消毒一次刀具和碗筷。
大家不用过于担心,虽然炎热的天气易导致“菌从口入”,但是只要保持饮食干净、卫生,预防这些细菌并不难。
还有一个特别重要的习惯,每个人都应谨记,并且做到——饭前、饭后勤洗手!

Comments are closed here.